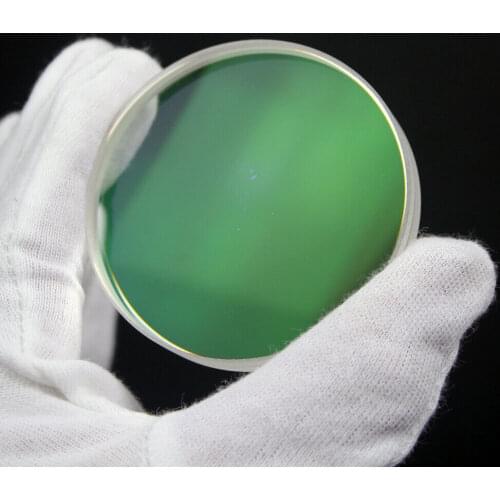
1PC 25.3mm/51mm/61mm/70mm Optical Glass Achromatic Objective Lens Cemented Lens FMC Coating DIY Telescope

New SRATE optical Lenses buy at Focusing & Measuring Store
132 Optical Lenses By SRATE Brand Found. Average cost items in Optical Lenses list is $17. The prices of SRATE goods correspond to others .
Price: $10.38
Old Price: $12.66Focusing & Measuring Store
Price: $16.59
Old Price: $19.98Focusing & Measuring Store
Price: $28.96
Old Price: $36.65Focusing & Measuring Store
Price: $30.89
Old Price: $34.32Focusing & Measuring Store
Price: $51.99
Old Price: $66.66Focusing & Measuring Store
Price: $17.77
Old Price: $18.89Focusing & Measuring Store
Price: $10.89
Old Price: $36.29Focusing & Measuring Store
Price: $15.14
Old Price: $19.66Focusing & Measuring Store
Price: $15.41
Old Price: $20.28Focusing & Measuring Store
Price: $53.49
Focusing & Measuring Store
Price: $13.78
Old Price: $14.66Focusing & Measuring Store
Price: $18.93
Old Price: $23.66Focusing & Measuring Store
Price: $9.86
Old Price: $12.66Focusing & Measuring Store
Price: $29.86
Old Price: $35.54Focusing & Measuring Store
Price: $405.45
Old Price: $445.55Focusing & Measuring Store
Price: $13.6
Old Price: $22.66Focusing & Measuring Store
Price: $10.17
Old Price: $12.55Focusing & Measuring Store
Price: $16.03
Focusing & Measuring Store
Price: $20.17
Old Price: $22.66Focusing & Measuring Store
Price: $9.76
Old Price: $11.22Focusing & Measuring Store
Price: $8.99
Old Price: $9.99Focusing & Measuring Store
Price: $32.56
Old Price: $36.58Focusing & Measuring Store
Price: $8.99
Old Price: $12.66Focusing & Measuring Store
Price: $51.03
Old Price: $58.66Focusing & Measuring Store
Price: $14.55
Focusing & Measuring Store
Price: $11.2
Old Price: $13.33Focusing & Measuring Store
Price: $10.37
Old Price: $12.65Focusing & Measuring Store
Price: $8.19
Old Price: $9.99Focusing & Measuring Store
Price: $12.42
Old Price: $14.28Focusing & Measuring Store
Price: $20.78
Old Price: $25.66Focusing & Measuring Store
Price: $51.21
Old Price: $55.66Focusing & Measuring Store
Price: $8.78
Old Price: $9.99Focusing & Measuring Store
Price: $11.93
Focusing & Measuring Store
Price: $8.61
Old Price: $8.88Focusing & Measuring Store
Price: $10.48
Old Price: $12.33Focusing & Measuring Store
Price: $11.14
Old Price: $12.66Focusing & Measuring Store
Price: $25.32
Focusing & Measuring Store
Price: $16.01
Old Price: $22.55Focusing & Measuring Store
Price: $13.66
Old Price: $16.66Focusing & Measuring Store
Price: $13.31
Old Price: $15.66Focusing & Measuring Store
Price: $25.17
Old Price: $27.66Focusing & Measuring Store
Price: $15.55
Focusing & Measuring Store
Price: $60.21
Focusing & Measuring Store
Price: $15.91
Focusing & Measuring Store
Price: $27.81
Old Price: $35.65Focusing & Measuring Store
Price: $28.18
Old Price: $31.66Focusing & Measuring Store
Price: $89.09
Focusing & Measuring Store
Price: $32.58
Old Price: $37.88Focusing & Measuring Store
Price: $16.71
Old Price: $19.66Focusing & Measuring Store
Price: $16.28
Old Price: $19.38Focusing & Measuring Store
Price: $16.05
Old Price: $18.88Focusing & Measuring Store
Price: $17.77
Old Price: $20.66Focusing & Measuring Store
Price: $12.74
Old Price: $14.99Focusing & Measuring Store
Price: $28.98
Focusing & Measuring Store
Price: $23.35
Old Price: $25.66Focusing & Measuring Store
Price: $13.31
Old Price: $15.66Focusing & Measuring Store
Price: $10.76
Old Price: $12.66Focusing & Measuring Store
Price: $14.36
Focusing & Measuring Store